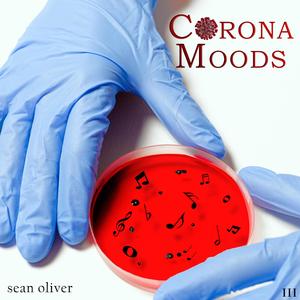
My Dog Is My Co-Worker Now

Sweetest Goodbye
Sean Oliver

You and Me (Radio Edit)
Sean Oliver

Everybody Loves the Sunshine
Sean Oliver

Lago
Sean Oliver

AirDam
Sean Oliver

Atmospheres
Sean Oliver

Night Trip
Sean Oliver

El Cabanyal
Sean Oliver

Flowers
Sean Oliver

Remember the Time?
Sean Oliver

Missing You Here.
Sean Oliver

My Dog Is My Co-Worker Now
Sean Oliver

The Brown Butt Lament
Sean Oliver

Thank God the Famous People Are Safe
Sean Oliver
I Think That Guy Just Sneezed on Me
Sean Oliver

Little Forest Parade
Cliff Sarde, Sean Oliver

You and Me
Sean Oliver

Dear Mary
Sean Oliver

Can I Flow?
Sean Oliver

Magic
Sean Oliver

The Rhythm
Sean Oliver

The Words
Sean Oliver

Solitaire
Sean Oliver

Need to Be Alone
Sean Oliver

Funny Love
Sean Oliver

These Are the Days
Sean Oliver

Driftin
Sean Oliver

Olive Juice
Seanrad

D.S
Oliver, 某只泽, 欧Ωhm, 初繁言

Flexin Flex feat.Oliver jiang
SeanT肖恩恩, Oliver Jiang

We’ll See (Sean Tyas & Waio Remix)
Simon Patterson

Mechanical
Oliver

Sean
aya

Thank You For Everything
Sean La'Brooy, Oliver Paterson

Is It Real (Tim Engelhardt & Sean Doron Remix)
Oliver Koletzki, Malou

Electrify
Oliver, Scott Mellis

迷途羔羊
Oliver

Light Years Away
Oliver

Last Forever
Sam Sparro, Oliver

Ottomatic
Oliver

Night Is on My Mind (Dillon Francis Remix)
Oliver

Sean
Trophy Eyes

The Box (Brainiac Remix) (Mixed)
Sean Tyas
![Blues Dance (Worldbeat) [feat. Pm & R.I.P]](https://p3.music.126.net/DesIH23vtcuCZoMZ1d3siA==/109951166092383473.jpg?param=300y300)
Blues Dance (Worldbeat) [feat. Pm & R.I.P]
Oliver Sean, PM, R.I.P
![Blues Dance (Worldbeat) [feat. Pm & R.I.P]](https://p3.music.126.net/rMSws4p-_rmw1FcWm-_Brw==/109951166193983951.jpg?param=300y300)
Blues Dance (Worldbeat) [feat. Pm & R.I.P]
Oliver Sean, PM, R.I.P

Fast Forward
Oliver

Last Forever (Lifelike Remix)
Oliver, Sam Sparro

Everyday Will Be Like a Holiday (feat. Nicki Kris, Christina Gaudet, Damian Wyldes, Syreeta Thompson, Trevor Sewell, Devin Leigh, Tomiko Dixon & Suzanne Grzanna)
Oliver Sean, Nicki Kris, Christina Gaudet, Damian Wyldes, Syreeta Thompson, Trevor Sewell, Devin Leigh, Tomiko Dixon, Suzanne Grzanna

Everyday Will Be Like a Holiday (feat. Christina Gaudet, Damian Wyldes, Devin Leigh, Nicki Kris, Suzanne Grzanna, Syreeta Thompson, Tomiko Dixon & Trevor Sewell)
Oliver Sean, Christina Gaudet, Damian Wyldes, Devin Leigh, Nicki Kris, Suzanne Grzanna, Syreeta Thompson, Tomiko Dixon, Trevor Sewell

Mexican Beer Song (feat. Nicki Kris, Syreeta Thompson Trumpetlady, Damian Wyldes, Devin Leigh, Christina Gaudet, Tomiko Dixon, Ej Ouellette, Lisa Coppola & R.I.P)
Oliver Sean, Nicki Kris, Syreeta Thompson Trumpetlady, Damian Wyldes, Devin Leigh, Christina Gaudet, Tomiko Dixon, EJ Ouellette, Lisa Coppola, R.I.P

Chemicals
Oliver, MNDR

Myb (Tchami Remix)
Oliver

Love Like This
Oliver, Leon Else

Go With It
Oliver, Chromeo

透明度
Oliver

Sean
Danny Elfman